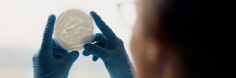
Hände mit blauen Handschuhen halten eine Petrischale in der Hand

- Home
-
Hochschule
- Aktuelles
-
Profil
- Zahlen, Daten, Fakten
- Selbstverständnis der HSBI
- Qualitätsverständnis
- Leitbild Lehre
- Lehrpreis
- Netzwerk Innovatives Lehren und Lernen (InnoLL)
- Prozessmanagement
- Familiengerechte Hochschule
- Diversity
- Weltoffene Hochschule
- Strategie Internationales
- Nachhaltigkeit
- Rückblick: 50 Jahre FH Bielefeld
- Feedback
- Fachbereiche
- Zentrale Organisation
- Standorte / Anfahrt
- HSBI-Portale
-
Studium
- Studienangebote
-
Beratung
- Studienorientierung
- Zentrale Studienberatung
- Studienfachberatung
- Psychosoziale Beratung
- Studienfinanzierung und Stipendien
- Schreibberatung
- Studieren mit beruflicher Qualifikation
- Studieren mit ausländischen Zeugnissen
- Studieren mit Handicap
- Studieren mit Familie
- Informationen für Schulen
- Auslandsaufenthalt
-
Bewerbung
- Auswahlgrenzen und Vergabeverfahren (NC)
- Bewerbungsportal
- Bewerbung Schritt für Schritt: Von der Bewerbung bis zur Einschreibung
- Bewerbung für ein höheres Fachsemester
- Bewerbung mit beruflicher Qualifikation
- Jungstudierende
- Gasthörerschaft und Zweithörerschaft
- Kontakt Studierendenservice
- Losverfahren
- Promotion
- Sonderanträge
- Studiengang wählen
- Wer kann an der HSBI studieren?
- Studienstart
-
Studium organisieren
- Studierendenservice
- Abschlussunterlagen
- Anerkennung von Leistungen
- Anträge einreichen
- Beurlaubung
- CampusCard
- Einreichung schriftliche Arbeiten
- Erstattung
- Exmatrikulation
- IT-Services
- Online-Serviceportale (LSF/CAT)
- Prüfungsangelegenheiten: Ordnungen, Modulhandbücher
- Rücktritt von einer Modulprüfung
- Rückmeldung
- Semesterbeitrag
- Semesterticket (Deutschlandsemesterticket)
- Semester-, Vorlesungs- und Prüfungszeiten
- Studienbezogene Auslandserfahrung
- Vorlesungsverzeichnis
- Rund ums Studium
- Fachbereiche
- Forschung
- Transfer
- Weiterbildung
- Internationales
- Karriere an der HSBI
Brasilianische Forscherin entwickelt im HSBI-Labor innovatives Verfahren zur Entwicklung eines biologischen Pflanzenschutzmittels
Die biologische Schädlingsbekämpfung ist in der Landwirtschaft gefragt als Alternative zu chemischen Pestiziden – auch und besonders in Brasilien. Im Bielefelder Institut für Angewandte Materialforschung der Hochschule Bielefeld hat die Gastwissenschaftlerin Dr. Natasha Sant‘Anna Iwanicki von der Universität São Paulo jetzt ein innovatives Verfahren entwickelt, mit dem die Pilze Metarhizium anisopliae und Beauveria bassiana in kommerziellen Produkten zur Schädlingsbekämpfung eingesetzt werden können. Durch Vorkonditionierung übersteht er die notwendige Trocknung besser und kann seine Wirkung auf dem Feld voll entfalten. Der Erfolg ist ein Ergebnis der gezielten Internationalisierung der HSBI-Forschung.
Bielefeld (hsbi). Mehrere Ernten pro Jahr und eine enorme Vielfalt an Feldfrüchten – Brasilien bietet dank seines günstigen Klimas und seiner enormen Fläche beste Bedingungen für die Landwirtschaft. Allerdings auch für Schädlinge. „Ihre Diversität ist ebenfalls außergewöhnlich hoch“, sagt Dr. Natasha Sant‘Anna Iwanicki bedauernd. Dann zeigt sie auf eine Petrischale mit einer bräunlichen Substanz und lächelt: „Aber sie haben natürliche Gegner.“ Ein Pulver? Nein, ein getrockneter Pilz: Beauveria bassiana.
Seit August vergangenen Jahres forscht Iwanicki als Gastwissenschaftlerin am Fachbereich Ingenieurwissenschaften und Mathematik der Hochschule Bielefeld (HSBI) in der Arbeitsgruppe „Fermentation and Formulation of Biologicals and Chemicals“ von Prof. Dr. Anant Patel, neben seiner Lehr- und Forschungstätigkeit auch Vizepräsident für Forschung und Entwicklung. Die promovierte Entomologin kennt sich nicht nur bestens mit Insekten aus, sondern als Agraringenieurin auch mit den Schädlingen unter ihnen.

„Immer wieder befallen Schädlinge Kulturpflanzen und sorgen für deutlich geringere Erträge“, so Iwanicki. Deshalb hat sich die 34-Jährige in ihrer Forschung an der Escola Superior de Agricultura Luiz de Queiroz (ESALQ) der Universidade de São Paulo auf Schädlingsbekämpfung spezialisiert – genauer: auf die in Brasilien immer gefragtere biologische Schädlingsbekämpfung. „Der Einsatz von lebenden Mikroorganismen wie Pilzen oder Bakterien ist deutlich sicherer für Umwelt, Erzeuger und Verbraucher als die Nutzung von chemischen Pestiziden“, sagt Iwanicki. Schließlich kommen die Mikroorganismen natürlicherweise in Böden, Wasser und Luft vor, sind mithin gut abbaubar. Und sie bevorzugen von Natur aus Schädlinge als Wirtstiere, die sie infizieren und am Ende auch ausschalten.
Wie kommt der Pilz auf’s Feld? Das beschäftigt Forschende in São Paulo und Bielefeld

Über das insektizide Potential von Mikroorganismen wie Metarhizium anisopliae und Beauveria bassiana besteht also kein Zweifel. Nur: „Wie bringen wir den Pilz gezielt auf’s Feld?“, fragt Natasha Iwanicki. Damit ist sie bei Anant Patel an der richtigen Adresse: Er forscht seit vielen Jahren intensiv zu biologischem Pflanzenschutz und ist Experte für Formulierungsmaterialien und -technologien, also für die Übertragung eines Wirkstoffes in eine technisch anwendbare Form. „Das ist oft die eigentliche Herausforderung in der Forschung“, sagt Patel. Er begrüßt die Expertise, die Natasha Iwanicki mitbringt: „Wir profitieren sehr vom Austausch mit den Wissenschaftler:innen aus São Paulo, die dortige Arbeitsgruppe zählt zu den besten weltweit. Diese Internationalisierung bereichert unsere Forschung mit anderen Herangehensweisen und Denkweisen.“
Erst kürzlich veröffentlichten Mitglieder beider Arbeitsgruppen in einem gemeinsamen Artikel ihre Forschungsergebnisse. Patel selbst war schon zu einem Gastaufenthalt an der ESALQ, und Natasha Iwanicki ist bereits die zweite Wissenschaftlerin der brasilianischen Arbeitsgruppe, die für ein Jahr an die HSBI gekommen ist. „Es ist toll, in solch einem gut ausgestatteten Labor und vor allem in Professor Patels hochqualifizierter und international renommierter Forschungsgruppe arbeiten zu dürfen!“ so Iwanicki.
Flüssigfermentation sorgt dafür, dass die Pilze in großer Menge und guter Qualität produzierbar werden

Für ein halbes Jahr hat sie auch gleich ihren Projektmitarbeiter Luiz Felipe Zumpano mitgebracht. Für den Bachelorstudenten ging neben den guten Forschungsbedingungen an der HSBI noch ein anderer Traum in Erfüllung: „Mein Urgroßvater stammt aus Deutschland, ich wollte unbedingt eine Zeitlang hier studieren.“ Ermöglicht hat das ein brasilianisches Stipendium, erleichtert hat es das Welcome Center der HSBI. „Das Team um Maximilian Köster hat uns großartig bei allen formalen Fragen unterstützt, vom Visum bis zur Wohnung“, betont Natasha Iwanicki. Sie ist international erfahren, hat u.a. in Norwegen studiert und dual promoviert an den Universitäten Kopenhagen und São Paulo.
So konnten Iwanicki und Zumpano gleich nach ihrer Ankunft mit der Arbeit im Labor beginnen. „Die aktuell erhältlichen Pflanzenschutzmittel auf Pilzbasis werden durch Festphasenfermentation hergestellt“, erläutert Iwanicki. „Das heißt, die Pilze werden auf Getreidesubstrat kultiviert, was zahlreiche Einschränkungen wie eine geringe Wachstumsrate, ungleiche Nährstoffverteilung und schwierige Prozesskontrolle mit sich bringt.“ Letztlich leidet die Qualität des biologischen Pflanzenschutzmittels. Die Forscherin öffnet einen Brutschrank, holt einen Erlenmeyerkolben heraus und schwenkt ihn prüfend hin und her: „Wir setzen dagegen auf die Flüssigfermentation. Das ist die Produktion der Pilze in einer Nährstofflösung. Denn dabei produzieren sie nicht nur verschiedene infektiöse Zellen für die Schädlingsbekämpfung, auch die Industrie bevorzugt dieses Verfahren, denn es lässt sich besser automatisieren und skalieren.“
Trocknung des biologischen Pflanzenschutzmittels bei extrem hohen Temperaturen
Für ein anwendbares Produkt braucht es den Pilz dann aber doch wieder in trockener Version. „So ist er länger haltbar und lässt sich besser lagern. Die Landwirte lösen ihn bei Bedarf in Wasser auf und bringen ihn auf dem Feld aus.“ Nur: Beauveria bassiana ist ein kleines Sensibelchen. „Er reagiert sehr empfindlich auf die erforderliche Trocknung“, verrät Natasha Iwanicki. Ihr innovativer Ansatz: „Vorkonditionierung. Wir verändern bei der Kultivierung verschiedene Parameter wie die Temperatur oder die osmotische Konzentration und setzen eine Schutzformulierung ein, also eine Art schützende Hülle.“ Mit dem Ziel, dass die so produzierten Pilzzellen die erforderlichen Eigenschaften entwickeln: „Sie sollen den Trocknungsprozess besser überstehen.“ Die Anforderung ist hoch, wie ein Gang in die Maschinenhalle der HSBI zeigt. Hier steht der Sprühtrockner der Arbeitsgruppe. Iwanicki und Luiz Zumpano setzen ihre Schutzbrillen auf und bringen die flüssige Pilzkultur ein. „Es wird jetzt sehr heiß“, kündigt Zampano an. In der Industrie werden zur Trocknung Temperaturen im mittleren bis hohen dreistelligen Celsius-Bereich eingesetzt. „Schnell muss es gehen“, sagt Iwanicki lächelnd. Und schon rieselt ein feines Pulver in den Auffangbehälter.
Um die optimalen Parameter für die Vorkonditionierung zu ermitteln, hieß es für die Forschenden: Experimentieren, experimentieren, experimentieren. „Wir waren von morgens bis abends im Labor“, sagt Luiz Zumpano. Er schaut aus dem Fenster zum Teutoburger Wald und lacht. „In den Wald habe ich es aber auch geschafft. Schön!“ Und schließlich hatten auch die Pilzzellen die erforderlichen Eigenschaften: Das Pulver lebt. Natasha Iwanicki freut sich: „Mit der Vorkonditionierung können wir die Lebensfähigkeit der Pilzzellen nach der Trocknung bei hohen Temperaturen deutlich verbessern.“

Auf sie wartet noch Pseudomonas protegens. Das Bakterium zählt ebenfalls zu den insektiziden Mikroorganismen, und Iwanicki will die Vorkonditionierung auch an ihm ausprobieren. „Die Experimente laufen noch.“ Bis zum Sommer ist noch Zeit, erst dann wird sie nach Brasilien zurückkehren. Für Luiz Zumpano heißt es jetzt schon Abschied nehmen. „Mir werden vor allem die Leute aus der Arbeitsgruppe fehlen“, sagt er ein wenig wehmütig. Worauf er sich neben Freunden und Familie am meisten freut? Die Antwort kommt prompt: „Brasilianisches Essen!“ – das für seine Pilzlastigkeit nicht gerade bekannt ist… (uh)
Für weiteres Bildmaterial können Sie sich gerne an presse@hsbi.de wenden.







